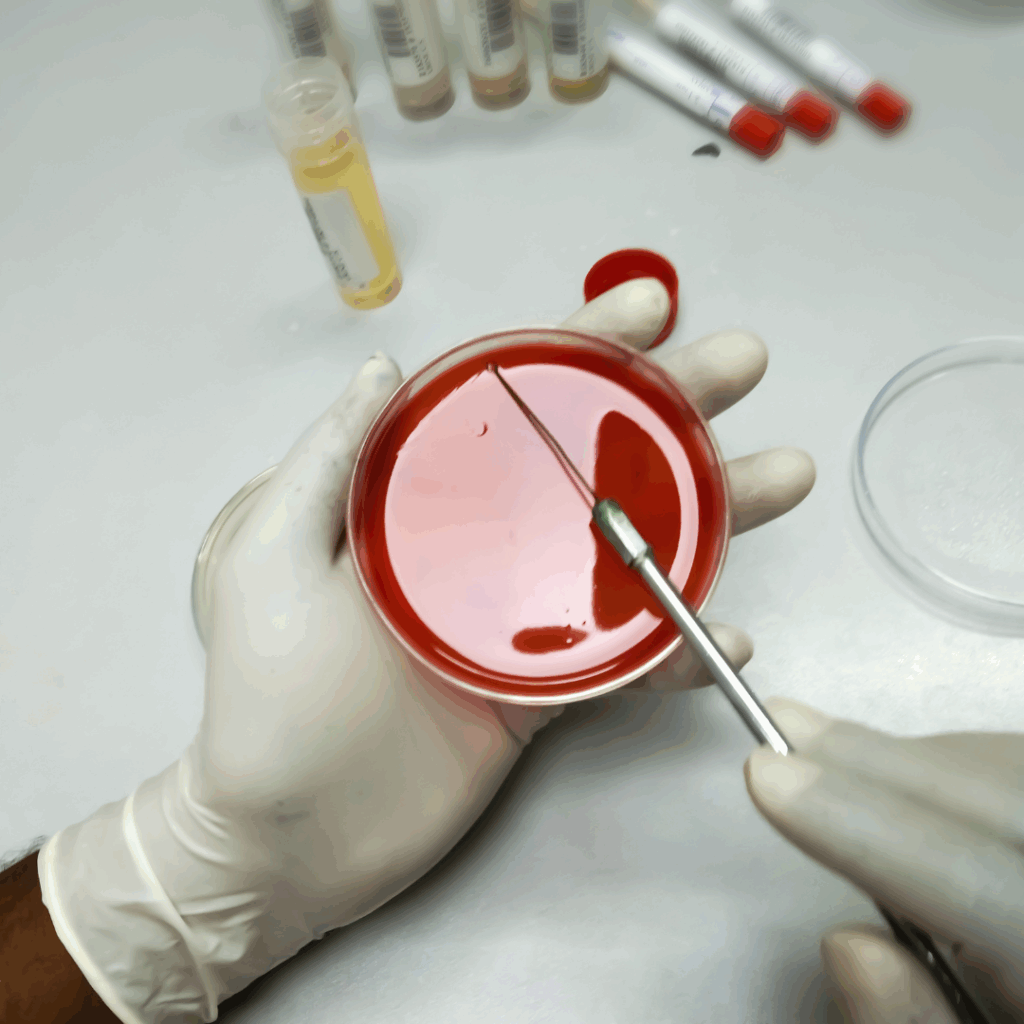
petri dish with agar

A urinary tract infection (UTI) and interstitial cystitis (IC) both cause similar symptoms, including painful and frequent urination, a strong urge to urinate and pelvic discomfort. However, the key difference between the two conditions is that a UTI is caused by inflammation from an infection of the bladder whereas IC involves similar symptoms without infection, or other clear cause. This key difference can typically be determined with a urine culture. A urine culture identifies any bacteria or fungus present in the urine. A positive urine culture indicates an infection, or UTI, is present.

IC is defined as an unpleasant sensation (pain, pressure discomfort) that localizes to the bladder, is present for more than six weeks and occurs without any infection or other clearly identifiable cause. We don’t know the exact cause of IC, but some theories include damage to the glycosamioglycan (GAG) layer, an autoimmune condition, nerve damage or dysfunction or pelvic floor muscle dysfunction. It is a diagnosis of exclusion, meaning there is no single test to diagnose IC and no single treatment to cure it.
Most women who experience a sudden episode of painful urination, frequency and urgency that resolves with antibiotics assume they have a UTI and do not worry that something else may be going on, especially given that up to 60% of women will have a UTI in their lifetime. However, it can start to get worrisome and confusing if symptoms don’t resolve with antibiotics, or recur shortly after. For some women, this recurrence or persistence in symptoms is due to recurring or relapsing UTI, whereas for others, it may be due to IC instead. The table below lists some key differences between the two conditions that can help provide the correct diagnosis.
| Feature | UTIs | IC |
| Urine culture results | Bacterial growth | No bacterial growth |
| Urinalysis results | Typically positive for white blood cells, red blood cells, leukocyte esterase and nitrites | Typically negative for white blood cells, red blood cells, leukocyte esterase and nitrites |
| Response to antibiotics | Symptoms typically resolve | Symptoms typically do not improve |
| Cloudy and foul smelling urine | Sometimes present | Not present |
| Blood in the urine | Sometimes present | Rarely present |
| Fever and chills | Sometimes present | Not present |
When to consider IC:
- You’ve had multiple “UTIs” but your urine cultures are negative.
- You have bladder or pelvic pain that comes and goes, and antibiotics don’t help.
- Your flares of symptoms are triggered by caffeine, spicy food, citrus, alcohol or acidic foods
What to do if you’re not sure:
- Every time you develop symptoms, ask your provider to check a urine culture—not just a dipstick, to determine whether bacteria and infection are present or not.
- Keep a bladder diary to track symptoms, activities as well as food and drink intake.
- See a urologist or urogynecologist for further workup if symptoms are persistent.
As mentioned above, the urine culture is the most important test to help determine whether your symptoms are due to UTI or IC. Doctors do not always send a urine culture for confirmation of diagnosis when a woman presents with painful urination, urgency and frequency and instead just treat with antibiotics, assuming it is due to a UTI. For most patients with a UTI, this approach is helpful because they can get rapid treatment with antibiotics with just a phone call or quick appointment. They don’t have to wait for test results or go to a lab. However, if you find yourself in a situation where your symptoms are not improving with antibiotics, or continue to recur, it is very important to ask your doctor to send a urine culture with each episode of symptoms.
It is important to note that if you have been diagnosed with IC, you can still get UTIs, and some patients with IC get recurrent UTIs in addition to their IC flares. For these people, it’s important to test the urine with a urinalysis and urine culture each time they have a flare to help determine whether UTI or IC is causing the symptoms.



